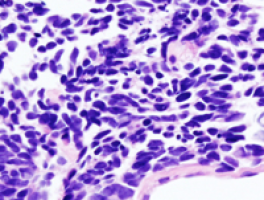
Prostate Cancer Survival Rates Improved Since Introduction of PSA Testing

The routine use of prostate specific antigen (PSA) testing for screening and monitoring prostate cancer has led to early and more sensitive detection of the disease.
A new study published in The Journal of Urology reports that in the “PSA era,” survival has improved for patients with newly diagnosed prostate cancer that has spread to the bones or other parts of the body and the disparity between African American and Caucasian men has been resolved.
“Our analysis indicates an overall improvement in risk adjusted survival rates for non-African American and African American men. Of note is the resolution of disparity in survival between the races found in earlier studies,” says lead investigator Ian M. Thompson, Jr., MD, Director of the Cancer Therapy and Research Center, a National Cancer Institute-Designated Cancer Center, and Professor in the Department of Urology at the UT Health Science Center at San Antonio, TX.
The Southwest Oncology Group, a National Cancer Institute (NCI) sponsored organization that conducts clinical trials in adult cancers, has performed a series of clinical trials over the last three decades that evaluated patient survival after androgen deprivation treatment (ADT) for prostate cancer.
Two of the trials took place before, and one took place after the introduction of PSA screening. “These sequential trials provide an opportunity to address the question of whether survival has improved since the advent of widespread PSA screening and follow-up testing,” says Dr. Thompson. Patient populations and eligibility criteria were comparable across the three studies, which enrolled patients from cancer centers around the country. Patients in all three trials received similar ADT treatments.
Median survival in trial S8494, which enrolled patients from 1985 to 1986, was 30 months, and median survival in trial S8894, which enrolled patients from 1989 to 1994, was 33 months. In contrast, median survival in trial S9346, which enrolled patients from 1995 to 2009, was 49 months. A 30% decreased risk of death was found in the most recent trial (S9346) from the previous trial (S8894).
The interaction of various risk factors, such as extensive versus minimal disease, older age, race, and body mass index was assessed. In S8494 the median survival for African American men was 27 months, while in S9346, the survival rate was 48 months, which is very close to that of white men.
Dr. Thompson notes that African American men had poorer results in the earlier studies despite receiving treatment in a carefully overseen clinical trial. “When we evaluated ZIP code summary information regarding income and education, there was no shift in socioeconomic status over time. We hypothesize that this improvement is based on greater awareness of prostate cancer and improved health seeking behavior in African American men.”
However, African American men have a two- to three-fold greater incidence of newly diagnosed metastatic prostate cancer compared to white men, which contributes to a similarly increased mortality rate. “A greater effort is needed to eliminate disparities in prostate cancer,” he says.
Dr. Thompson concludes, “While not all of these welcome improvements can be attributed strictly to PSA testing, without a doubt it has played a role in extending many lives,”
Source: Elsevier